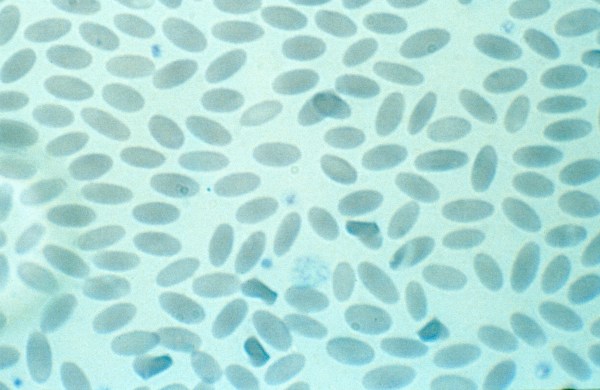
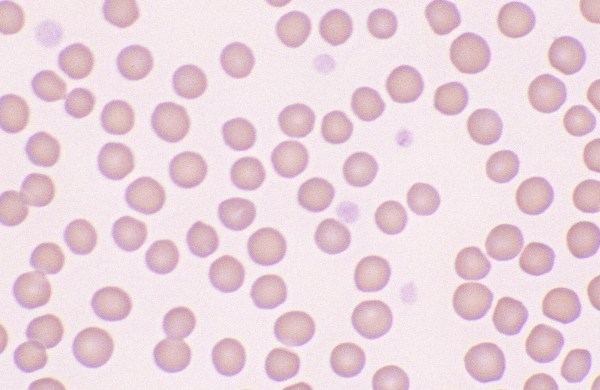

Avian: mature erythrocytes are oval cells with pink-orange cytoplasm and a dark blue nucleus located centrally. Immature erythrocytes have a round shape, a lighter blue nucleus, and light blue cytoplasm. Avian erythrocytes… Read more Exotics →

Morphology: small red blood cells with mild anisocytosis and little to no central pallor. Lifespan: 150 days Other features: slight poikilocytosis may be normal. Crenation of red blood cells with sharp-pointed margins is… Read more Normal Sheep Erythrocytes →

Morphology: very small red blood cells with mild anisocytosis and little to no central pallor. Goats have the smallest erythrocytes of all domestic species. Lifespan: 125 days Other features: prominent poikilocytosis may be… Read more Normal Goat Erythrocytes →

Morphology: red blood cells often show artifactual crenation (sharp-pointed margins) with little to no central pallor and mild to moderate poikilocytosis. Lifespan: 70 – 98 days Other features: rouleaux is common. Young… Read more Normal Porcine Erythrocytes →

Morphology: llamas, alpacas, and camels have small, flat, oval-shaped red blood cells. Lifespan: 60 days Other features: mild anisocytosis and poikilocytosis may be present in healthy llamas. Mean corpuscular hemoglobin concentration (MCHC) in… Read more Normal Camelid Erythrocytes →

Morphology: relatively small, uniform red blood cells with little to no central pallor. Lifespan: 140 – 150 days Other features: rouleaux may be prominent in healthy horses. Polychromatophils are not observed in blood… Read more Normal Equine Erythrocytes →

Morphology: relatively small red blood cells with mild anisocytosis and a small amount of central pallor. Lifespan: 160 days Other features: basophilic stippling common with regenerative response. Young calves (< 3 months) may show… Read more Normal Bovine Erythrocytes →

Morphology: relatively small red blood cells with some variability in size and shape and little to no central pallor. Lifespan: 65 – 76 days Other features: rouleaux, occasional Howell-Jolly bodies, and… Read more Normal Feline Erythrocytes →